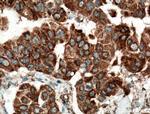
SMYD3 Antibody in Immunohistochemistry (Paraffin) (IHC (P))

Search
Proteintech
SMYD3 Polyclonal Antibody
{{$productOrderCtrl.translations['antibody.pdp.commerceCard.promotion.promotions']}}
{{$productOrderCtrl.translations['antibody.pdp.commerceCard.promotion.viewpromo']}}
{{$productOrderCtrl.translations['antibody.pdp.commerceCard.promotion.promocode']}}: {{promo.promoCode}} {{promo.promoTitle}} {{promo.promoDescription}}. {{$productOrderCtrl.translations['antibody.pdp.commerceCard.promotion.learnmore']}}
产品信息
12011-1-AP
种属反应
已发表种属
宿主/亚型
分类
类型
抗原
偶联物
形式
浓度
规格
纯化类型
保存液
内含物
保存条件
运输条件
产品详细信息
Immunogen sequence: MRCSQCRVA KYCSAKCQKK AWPDHKRECK CLKSCKPRYP PDSVRLLGRV VFKLMDGAPS ESEKLYSFYD LESNINKLTE DRKEGLRQLV MTFQHFMREE IQDASQLPPA FDLFEAFAKV ICNSFTICNA EMQEVGVGLY PSISLLNHSC DPNCSIVFNG PHLLLRAVRD IEVGEELTIC YLDMLMTSEE RRKQLRDQYC FECDCFRCQT QDKDADMLTG DEQVWKEVQE SLKKIEELKA HWKWEQVLAM CQAIISSNSE RLPDINIYQL KVLDCAMDAC INLGLLEEAL FYGTRTMEPY RIFFPGSHPV RGVQVMKVGK LQLHQGMFPQ AMKNLRLAFD IMRVTHGREH SLIEDLILLL EECDANIRAS (60-428 aa encoded by BC031010)
靶标信息
SMYD3 (histone-lysine N-methyltransferase) methylates Lys-4 of histone H3 and Lys-5 of histone H4. It induces di- and tri-methylation. SMYD3 plays an important role in transcriptional activation as a member of an RNA polymerase complex.
仅用于科研。不用于诊断过程。未经明确授权不得转售。
生物信息学
蛋白别名: Histone-lysine N-methyltransferase SMYD3; SET and MYND domain-containing protein 3; SET domain; unnamed protein product; Zinc finger MYND domain-containing protein 1; zinc finger protein, subfamily 3A (MYND domain containing), 1; zinc finger, MYND domain containing 1
基因别名: 2410008A19Rik; bA74P14.1; KMT3E; SMYD3; ZMYND1; ZNFN3A1
UniProt ID: (Human) Q9H7B4, (Mouse) Q9CWR2
Entrez Gene ID: (Human) 64754, (Mouse) 69726, (Rat) 498295